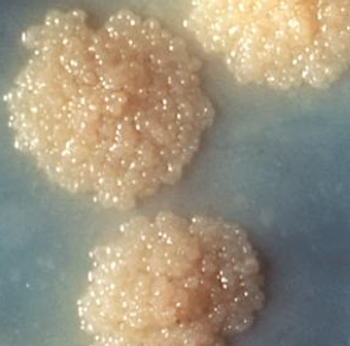

The Direct Decision Support Model was designed to provide medical information to approximately 700,000 Medicare beneficiaries.

The Direct Decision Support Model was designed to provide medical information to approximately 700,000 Medicare beneficiaries.

Dr. Google has its place, but Dr. Sarah Hawley believes that for patients to make the right decisions about their cancer care, they'll need the right information.

Are patients as enamored with mHealth as hospitals want them to be?

In a new survey, just 18% of patients said they use telehealth services.

Still, the European e-health tool shows clinical promise, researchers say.

A platform designed to help people remain in recovery is telemedicine’s latest tool.

The 5-year-old disruptor finds a friend in 200-year-old French insurance giant.

Wearables and personal health monitors have impressive capabilities, but a new review from Cedars-Sinai indicates that they don't often affect behavioral change.

Using telehealth to combine the efforts of school nurses with the knowledge of a PCP yielded better outcomes for children with asthma in a poor urban environment.

One of the country’s leading insurers is looking toward digital payments, video, and more.

The platform’s groups are an “essential part of the learning environment” in at least 1 school.

The potential of new tech, from wearables to telehealth platforms, is undeniable: But how can all this stuff be made both cool and credible?

Researchers set out to see how holidays, weekends, and time of day affected the use of food-recording smartphone apps.

How he hopes to further the growing telehealth company.

Two groups that control $2 billion worth of Apple stock are urging the company to weigh in on the scientific tug-of-war that surrounds the role of smartphones in mental health.

The bipartisan Veterans E-Health and Telemedicine Support Act was passed by the Senate unanimously this week.

Why healthcare should carry these lessons into the new year.

Before the initiative, the disease had killed 6 men in a mental health facility.

Still, only 36% reported wishing for a return to paper (although 11% answered that they were "unsure.")

Throughout its inaugural year, Healthcare Analytics News™ closely covered developments in telehealth technologies, markets, and regulations. These are 5 of the best.

The experts have weighed in. These are the healthtech companies that won 2017.

The bill would give medical clearinghouses some HIPAA exemptions, allowing them to give patients access to their EHRs—and charge a fee to do so.

Activbody is donating 200 data-driven mobile health devices to children in New York.
The CDC says it learned crucial lessons after prior storms.

The healthcare system’s average “door-to-needle” time is now 34 minutes, a decrease of nearly 20 minutes.